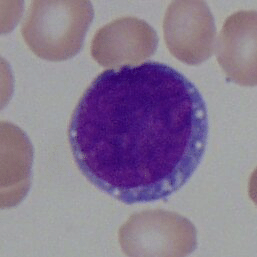
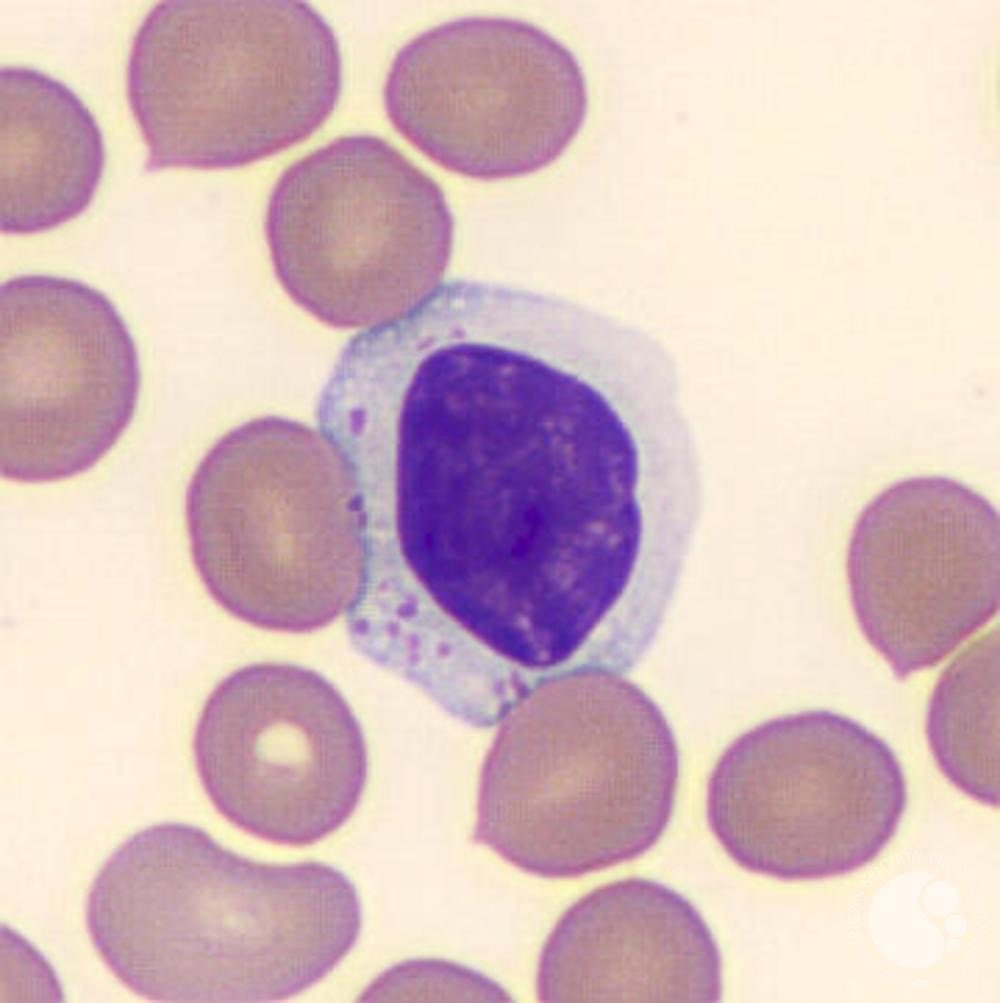

Lymphocyte maturation and functions
1/16
There's no tags or description
Looks like no tags are added yet.
Name | Mastery | Learn | Test | Matching | Spaced |
|---|
No study sessions yet.
17 Terms
What are the three lymphocyte maturation stages?
lymphoblast
prolymphocyte
lymphocyte (small and large)
Describe the general characteristics of a lymphoblast (size, chromatin, cytoplasm, N:C ratio).
size: 16-24 um
chromatin: fine and grainy looking, some nucleoli
cytoplasm: deeply basophilic
N:C ratio: high, very round oval nucleus
Describe the general characteristics of a prolymphocyte (size, chromatin, cytoplasm, N:C ratio).
size: 18-28 um
chromatin: condensing, some blocks
cytoplasm: deeply basophilic, but more abundant
N:C ratio: moderate, nucleus has shrunk

Describe the general characteristics of a lymphocyte (size, chromatin, cytoplasm, N:C ratio).
size: 8-12 (small) or 12-15 (large) um
chromatin: condensing, more blocky
cytoplasm: pale blue
N:C ratio: moderate

Describe the shaping and N:C ratio of a small lymphocyte.
very round, including nucleus, almost the same size as an RBC
N:C ratio is high

Describe the shaping and N:C ratio of a large lymphocyte.
irregular borders and shape with nucleus
chromatin is a little lighter than a small lymph
N:C ratio is moderate

What characteristic may differentiate between a small and large lymphocyte besides size?
presence of purple granules
Describe the general characteristics of a plasma cell (size, chromatin, cytoplasm, nucleus shape).
size: 14-20 um
chromatin: in a wheel spoke shape
cytoplasm: deep blue except for the golgi that hangs out along one side of the nucleus
nucleus shape: eccentrically placed, oval, one flat-ish side

What are five CD markers on the surface of a B-cell?
CD45, 20, 19, 32, 21
What are the functions of a B-cell?
produce antibodies as plasma cells
retain memory
have IgM or IgD on surface of cells
produce IgA as 1st line of defense in mucosal surfaces
What are the functions of T-cells?
protect against intracellular pathogens
help activate B-cells and macrophages
APC interactions
IL-2 and IFN-gamma secretion from T-helper cells
form rosettes when interacting with sheep RBCs

What cells typically constitute null lymphocytes?
NK cells or lymphocytes that have lost their CD markers
Which cell population secretes IL-1? What is the function of IL-1?
macrophages and monocytes
fx: to activate CD4 T-cells and raise body temperature through CNS signaling
Which cell population secretes IL-2? What is the function of IL-2?
T-helper cells
fx: expansion and activation of other lymphocytes and NK cells
What are some other lymphokines that T-helper cells secrete?
BCGF, BCDF, and IFN-gamma
What is the function of IFN-gamma?
to inhibit viral replication, inhibit TH2 cells, activate macrophages
What are the functions of BCGF and BCDF?
BCGF - growth factor, so it helps stimulate growth of B-cells
BCDF - differentiation factor, so it helps differentiate immature B-cells to effector cells